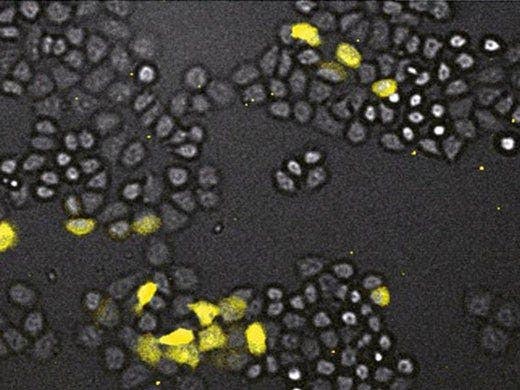
HeLa cells using GL3 luciferase

LV200
Permettendo uno studio di dettaglio di cellule fotosensibili e sonde a luminescenza a elevato ingrandimento, il flusso del gas, l'umidità e il controllo della temperatura integrato del sistema di imaging a bioluminescenza LV200 proteggono le cellule in coltura e le sezioni di tessuto durante l'osservazione per periodi prolungati. Lo speciale design ottico del sistema permette un imaging a bioluminescenza ad alto ingrandimento e il telaio a tenuta protegge il campione e le ottiche dalla luce esterna.
Avanzata struttura ottica per assicurare un'elevata sensibilità
Maggiore risoluzione rispetto ai tipici sistemi di microscopia a luminescenza
Disponibili numerose opzioni di ingrandimento
* Questo prodotto è fuori produzione e non esiste un prodotto sostitutivo.

Overview

A Quantum Leap in Live Cell Imaging
The LV200 has been carefully designed for long-duration cell bioluminescence. A completely new optical design dramatically increases sensitivity and enables the detailed study of photosensitive cells and luminescence probes at high magnification. The built-in system for temperature control, humidity and gas flow helps to keep the cultured cells or tissue slices in a healthy condition throughout the observation period and the unique light-tight enclosure shields the sample and optics from any external light.
Cell-friendly Imaging
Luminescence comes from within the sample and is in turn non-toxic to the cells. There is also no background noise or autofluorescence to worry about. Luminescence is, therefore, the right light for live cell imaging.
Advanced Bioluminescence Microscopy
Luminescence has several potential benefits over fluorescence including better signal-to-background ratios due to the lack of background emission and no phototoxicity nor photobleaching, making it ideal for quantitatively following long-term changes in live cell systems. The observation of luminescence has previously been held back by a number of technical challenges. In the LUMINOVIEW LV200, Olympus has successfully developed a luminescence microscope system that overcomes these challenges and harnesses the power of bioluminescence imaging for the first time in a commercial system.
Overcoming the Limitations of Fluorescence
Fluorescence microscope and related techniques have many advantages, but also a number of limitations. Bioluminescence imaging has the potential to overcome these limitations. The unique optical design of the new Olympus LV200 brings together the advantages of fluorescence and bioluminescence to create a system capable of acquiring bright, high- resolution images.

Fluorescence
Fluorescent emissions tend to be short-lived and bright, requiring specific frequencies of light for excitation. As a result, this illumination is required at the time of imaging, which means that the optical system must be able to supply strong and fully controllable light at one wavelength and project the emitted light on a different wavelength to the user’s eyes and/or camera. Despite these relatively complex optical requirements, fluorescence techniques have flourished and are enabling groundbreaking discoveries in many research areas.
Bioluminescence Imaging
Luminescence emissions tend to have varying lifetimes and are often quite faint, but due to the lack of background or fluorescence they can be measured with a high signal-to-noise (S/N) ratio. This makes luminescence ideal for applications where there is strong autofluorescence, such as whole animal imaging or in samples containing various compounds from chemical libraries. The in vivo imaging systems and microplate luminescence readers have shown great success in these areas.
High Signal/Noise Ratio without Bleaching/Toxicity
Bioluminescence imaging has great advantages over fluorescence imaging since it combines a high S/N ratio with no bleaching/phototoxic effects. What is more, only viable cells emit luminescence signals since emission is only possible with a functioning metabolism. As a result of this, bioluminescent measurements are ideal for sensitive living cells and are absolute and directly quantitative. These advantages are now no longer limited to macro imaging and bulk measurement, but can now also be applied to high-resolution microscopy.
High-quality Images
Olympus has developed the LV200 LUMINOVIEW bioluminescent imaging system, which provides amazingly detailed images using standard CCDs rather than specialized photon detectors. To do this, the optical design of the system is highly specialized to maximize light collection - an essential aspect, given the low levels of light emitted.
An Optimized Light Path
The light path from the object to the camera is straight and as short as it can be to ensure that as much light as possible reaches the CCD chip. There is also no need for any additional mirrors, filters or lenses which absorb light, reducing the signal even further. Furthermore, the tube lens has been designed with an extremely high numerical aperture (NA), which affords a vast increase in sensitivity when compared to conventional microscope optics. As a result, the LV200 produces signal outputs many times higher than traditional systems and can, therefore, be used with conventional CCD or EM-CCD cameras. The LV200 can use different magnifications from 0.8x to 20x, enabling it to clearly image samples from large brain sections down to individual cells.

Higher Resolution Imaging
These unique optical properties ensure exquisite single-cell resolution not previously possible with luminescence imaging. These improvements, along with the number of luminescent probes now available, promise to take microscope imaging to a different level. These properties also enable excellent spatial resolution, so that weak signals near areas with high signals can be differentiated with great ease, which is not possible on a luminometer.
Use in Normal Lab Environment
The light-tight enclosure of the LV200 shields the samples and optics from external light and allows the microscope to be used under ambient light in the laboratory. For applications or samples that require very long exposure times, the microscope might have to be moved to a low-light room.
Expanding Current Imaging Capabilities
With optical components optimized for the detection of luminescent light, the LV200 is further designed to match the requirements of a broad range of research. It has integrated excitation and emission filter wheels to enable dual-color luminescence as well as transmitted light fluorescence imaging. With standard brightfield illumination and phase contrast inserts, target areas of the sample can be found easily before switching to luminescence detection. It is, therefore, also possible to produce luminescent and fluorescent overlays on brightfield images, which enables localization and colocalization capabilities that were not previously possible.


Incubated
With the system now capable of long-term imaging, it is important that samples can be left on the stage for the entire time of the imaging experiment. The LV200 is designed so that samples can be placed inside a highly accurate environmental chamber, which has independent temperature control for the stage, incubation chamber, top cover and objective. Furthermore, a water reservoir is used to maintain the correct humidity level, and CO2 flow control enables pH stability. Such environmental control enables samples to be continuously monitored over days or even weeks, without the need to move the sample between the microscope and an incubator.
Specifications
Light-tight dark box
Manual objective lens focusing
Coaxial XY stage
Motorized exciting filter wheel with 3 positions for
Condenser for transmission brightfield coupled to light guide standard 25 mm optical filters
C-mount for camera
Tube lens optimized for luminescence imaging, 0.2 X magnification
Double-layered chamber type incubator for 35 mm dish including controller, stage heater, top cover heater,
main body heater, objective heater, flow meter for 5 % CO2, 95 % air
Depending on application and required sensitivity, cooled CCD cameras, EM-CCD cameras or deep-cooled slow-scan
CCD cameras can be used. (Please ask about camera/software compatibility.)
Main unit 850 VA
Controller 840 VA
Recommended Objectives
Applications
HeLa cells using GL3 luciferase
NIH/3T3 cell

Mouse NIH3T3 fibroblasts

Luciferase, GFP and brightfield

HeLa cells

CHO cells

Bilateral SCN

LUC luciferase

LUC luciferase

Resources
Brochures
Videos
LV200: Gadi Bmalluc Transient